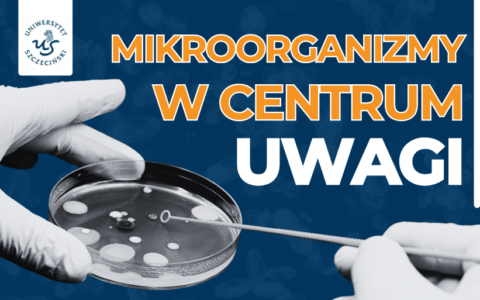
Podsumowanie konferencji z okazji Światowego Dnia Mikroorganizmów

Zgłoszenia na Igrzyska Studentów Trzeciego Wieku
14 listopada 2025 roku odbędą się Igrzyska Studentów Trzeciego Wieku – organizowana przez Klub Uczelniany Akademickiego Związku Sportowego Uniwersytetu Szczecińskiego ogólnopolska akcja skierowana do seniorów powyżej 55. roku życia. Wydarzenie będzie typową grą miejską, w której każdy uczestnik lub drużyna musi wykonać szereg zadań w odpowiednim miejscu i czasie.
Czytaj więcej →

Erasmus+ to program Unii Europejskiej w dziedzinie edukacji, szkoleń, młodzieży i sportu na lata 2014-2020.
Galeria zdjęć dokumentująca wydarzenia organizowane na Uniwersytecie Szczecińskim.
Pliki do pobrania. Logo, godło, księga identyfikacji wizualnej.


Uniwersytet Szczeciński od momentu rozpoczęcia działań wojennych na Ukrainie, oferuje różne formy pomocy obywatelom ukraińskim.